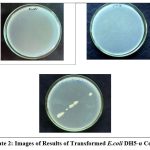

Manuscript accepted on : 12-09-2025
Published online on: 29-09-2025
Plagiarism Check: Yes
Reviewed by: Dr. Sonam Sneha
Second Review by: Dr. M M V Baig
Final Approval by: Dr. Eugene A. Silow
Biotechnological Optimization of Switchgrass: In Vitro Regeneration and Endoglucanase E1 Transgenic Approaches to Boost Biofuel Efficiency
Rojin George
, Elizabeth Sahmicit Dashe
and Josiah Chukwudi Onovo*
ABSTRACT:
Department of Plant Science and Biotechnology, Nasarawa State University, Keffi-Nigeria.
Corresponding Author E-mail:onovojos@nsuk.edu.ng
KEYWORDS: Acidothermus cellulolyticus; Endoglucanase E1 gene; Callus cultures; In vitro cultures; Switchgrass (Panicum virgatum L.); Transfected callus; Transgenic switchgrass
| Copy the following to cite this article: George R, Dashe E. S, Onovo J. C. Biotechnological Optimization of Switchgrass: In Vitro Regeneration and Endoglucanase E1 Transgenic Approaches to Boost Biofuel Efficiency. Biotech Res Asia 2025;22(3). |
| Copy the following to cite this URL: George R, Dashe E. S, Onovo J. C. Biotechnological Optimization of Switchgrass: In Vitro Regeneration and Endoglucanase E1 Transgenic Approaches to Boost Biofuel Efficiency. Biotech Res Asia 2025;22(3). Available from: https://bit.ly/4nZamOS |
Introduction
The North American tallgrass prairies are home to switchgrass, a warm-season perennial C4 grass that is a member of the subfamily Panicoideae of the Poaceae family.1,2 Switchgrass may flourish on poor soils, produce a lot of biomass, and give farmers a new way to make money while also helping the environment.3
An upright bunchgrass that can reach a height of 4 meters, switchgrass is known for its excellent yields.4 Access to fermentable sugars is hindered by structural and chemical barriers known as recalcitrance, making the production of ethanol from lignocellulosic biomass more challenging than from starch-based sources.5 By improving its total and net energy yield per hectare, switchgrass can become a more economically viable dedicated energy crop if its biomass productivity is improved.6, 7
There is great promise for the herbaceous plant switchgrass as a long-term bioenergy crop. A highly desirable biofuel feedstock, it produces a lot of biomass, can grow in a variety of temperatures, and doesn’t compete too much with food crops. Potentially meeting a large portion of the world’s transportation fuel demands with far less environmental damage than fossil fuels, biofuels made from non-grain lignocellulosic materials with high biomass yields are an attractive renewable energy option. Rapid and regulated growth of switchgrass plant materials is made possible through in vitro culture, a potent instrument in plant biotechnology. Biofuel production can be improved by genetic engineering by introducing features including higher sugar content, decreased lignin content, and improved enzymatic digestibility. In order to successfully create and select high-performing genetically modified switchgrass types specialized for biofuel generation, it is important to build precise and reproducible techniques for in vitro cultivation of the grass and molecular screening.
Bioconversion into ethanol is more challenging for lignocellulosic biomass due to its complex composition of cellulose, hemicellulose, and lignin compared to feedstocks based on starch.8,9 The existing biomass fermentation processes for fuels and chemicals are expensive due in large part to this intrinsic resistance, which has prevented cellulose ethanol from being commercialized on a large scale.10 Removing the structural and chemical obstacles to biomass breakdown in bioenergy crops is crucial for enabling sustainable energy generation.11
The inaccessibility of sugars locked within plant cell walls to cellulase enzymes is a major barrier to the efficient and economical synthesis of cellulosic ethanol. Enzymes are necessary for breaking down complex carbs into fermentable sugars, but they have a hard time breaking down cellulose and hemicellulose because of how closely bonded the sugar components are. An efficient method of propagating switchgrass is in vitro culture, which allows for the production of several plants with identical genetic material from a single tissue sample. For the purpose of propagating a homogeneous plant population, this is helpful. Because they necessitate the adjustment of growth medium, hormone therapies, and sterilizing processes, in vitro culture regimens can be difficult to create. It is absolutely essential to keep the culture sterile in order to avoid infection. Optimal growth medium composition, lighting, and hormone levels are only a few of the species-specific considerations that go into designing in vitro culture techniques for switchgrass. One of the most important steps in plant genetic engineering is in vitro culture.
Reducing the price of creating cellulosic ethanol is a promising area for plant genetic engineering. Switchgrass and other plant species can have their biomass yield increased by genetic engineering, making them more useful as feedstocks for cellulosic ethanol generation. As a result, production costs are reduced and ethanol yield is increased per unit of land and resources. To find genetically modified switchgrass varieties with improved biofuel-related properties, more accurate molecular screening approaches are needed.
Materials and Methods
The seeds for the switchgrass came from Houghton, USA’s Michigan Technological University. The Department of Plant Science and Biotechnology at Nasarawa State University, Keffi, in conjunction with Contec Global Agro Ltd of Maitama, Abuja, carried out the initial field investigations and domestication attempts. Trichy Research Institute of Biotechnology, Pvt. Ltd. in India was responsible for the genetic modification (GMF) component.
The induction of numerous shoots from nodal explants was achieved by preparing Switchgrass (Panicum virgatum L.) in vitro nodal cultures using MS12 media. Benzylaminopurine (BAP), Kinetin (Kn), Indole Acetic Acid (IAA), Indole Butyric Acid (IBA), and Naphthalene Acetic Acid (NAA) were among the growth hormones used to stimulate shoot regeneration. The quantities of these hormones were varied, from 0 to 2 mg/l. Tables 1 and 2 detail the hormone concentrations and combinations, and the therapy codes that relate to them. As a control, hormone-free MS media was utilized. To continue multiplying shoots and maintaining the culture, the medium with the maximum yield was chosen. The regenerated shoots were periodically grown in new media at 30-to 60-day intervals. With each treatment, 20 explants were used in each of the six replicates. We used SPSS version 22’s Analysis of Variance (ANOVA) to look for trends in the data, and Duncan’s Multiple Range Test to find out how much the means differed.
Methods for Inducing Root Growth in Switchgrass (Panicum virgatum L.) Shoots That Have Regenerated or Derived Calluses in a Laboratory Setting
Regenerated shoots (2–5 cm) taken from nodal tissues were subjected to in vitro root induction using growth regulator-supplemented or unsupplemented medium. Shoots grown from nodal explants were given the best possible rooting environment by using MS media as the basal medium. Several different hormone-supplemented half-strength MS medium were used to transplant these numerous shoots. For the purpose of conducting more trials, the modified medium that produced the maximum number of roots per shoot was chosen. One month following the start, the length of the roots was measured from the base of the shoot to the tip of the root using a centimeter scale. After two months, we counted the amount of roots that had grown on each plantlet. Table 3 summarizes the various treatments combining different media (MS, B5, and their mixture) with varying concentrations of Kinetin (Kn) and 2,4-Dichlorophenoxyacetic acid (2,4-D) for optimizing callus induction protocols in switchgrass.
Table 4 presents a summary of the medium compositions utilized to root numerous shoots from nodal explants. Shoot regeneration from callus cultures of switchgrass (Panicum virgatum L.) was evaluated using different concentrations of cytokinins (BAP and Kn) either alone or in combination with auxins (NAA, IAA, and IBA). (Table 5) Days to Bud Break, Shoot Length, Leaf Length, Width and Number of at 2 Months of Culture in MS Medium is presented in Table 6.
The most successful root formation, at 93.33%, was observed in SGR2 (1/2 MS + 1mg/L NAA), followed by SGR6 (1/2 MS + 0.5mg/L NAA) at 80%, and SGR4 (1/2 MS + 0.5mg/L NAA + 0.5mg/L IAA) at 50%. A statistically significant difference (P < 0.05) was noted among the treatments concerning the number of days required for root induction, as detailed in Table 7.
The hormonal combinations SGC-19 (MS- B5 kinetin 0.1mg/1 + 2 4D 2mg/1) and SGC-20 (MS- B5 kinetin 0.5mg/1 + 2 4D 2mg/1) can be considered as most advantageous for callus induction for switchgrass as they provided highest callus induction percentage (74% and70%).
Results
Preparation of Switchgrass (Panicum virgatum L.) invitro nodal culture
For both shoot induction and growth, MS medium proved to be the most effective, regardless of the hormone amounts tested. After 28 days, the maximum shoot induction was reached in SG2 (MS+0.3mg/l BAP), whereas the slowest induction was observed after an average of 58 days. The shoot induction time for SG6 was the longest at 58 days, followed by SG9 at 50 days, and SG 10 at 53 days.
Growth Study of Multiple Shoots after 2 Months of Culture Period
After 60 days of culture in MS medium, the SG2 (MS media supplemented with 0.3mg/l BAP) had the highest multiplication rate, with an average of 11 shoots/explant. Then came SG 3 and SG 4, which used MS medium supplemented with BAP at concentrations of 0.5 and 1 mg/l, respectively, and a total of 9.00 and 8.00 shoots/explants. In the control group (SG 1), no shoots were observed.
Treatment number SG2 (MS+0.3mg/l BAP) resulted in bud break after 12 days, shoot height of 10cm, leaf length of 17 cm, and width of 0.30 cm. Treatment number SG 3 (MS + 0.5mg/l BAP) followed with bud break after 14 days, shoot height of 5.4 cm, leaf length of 11 cm, and width of 0.20 cm. Treatment number 4 (MS + 1mg/l BAP) resulted in bud break after 17 days, with average shoot height of 5.2 cm, leaf length and width of 9 and 0.10 cm, respectively. After 28 days, with leaf height and width of 4cm and less than 0.1cm, respectively, the bud break for treatment number SG5 was seen. After 35 days, treatment number SG 6 (MS medium supplemented with 2mg/1 BAP and 0.8mg/1 IBA) caused the buds to break. The minimum average shoot length was 1.23cm, and the leaf height and width were 5cm and <0.1cm, respectively. Treatment number SG 7 had four leaves and a bud break after 38 days, with a leaf height of 11 cm and a leaf breadth of less than 0.1 cm. After 38 days, treatment number SG 8 showed bud break with 4 leaves, a leaf height of 9cm, and a leaf width of less than 0.1cm. After 43 days, bud break was noted for treatment SG9 and SG10, with leaf height and width measuring less than 5 cm and less than 0.1 cm, respectively. Treatment SG 2 had the highest number of leaves at 11, followed by treatments SG 3 and 4, with 7 and 5 leaves, respectively.
Following a two-month culture period, the treatment number SG2 (MS+0.3mg/l BAP) had the longest average shoot length at 10 cm, followed by SG 3 (MS + 0.5mg/l BAP) at 5.4 cm and SG 4 (MS + 1mg/l BAP) at 5.2 cm. Treatment SG 6 (MS+2mg/1 BAP + 0.8mg/1 IBA) had the shortest average shoot length at 1.23 cm. In SG2 (MS+0.3mg/l BAP), the greatest number of shoots was 12. No MS media concentration was as effective as the SG2 treatment (MS+0.3mg/l BAP).
Callus Induction
MS-B5 combined medium produced stable callus for Switchgrass (Panicum virgatum L.). Callus produced from the media was brittle and brown, which allowed for easy multiplication and transfer. This morphology is consistent with descriptions of callus previously shown in maize. Callus formed faster, after 4 weeks on MS-B5 combined medium from the clumps of in vitro switchgrass cultures.
Organogenesis in switchgrass (Panicum virgatum L.)
Among the media utilized, the treatment SGO2, which consists of MS supplemented with 0.3 mg/l BAP, successfully prompted the formation of shoots.
Cloning and Expression of Endoglucanase E1 Gene from Acidothermus cellulolyticusinto Switch grass
The BLAST software for the construction of primers for PCR is presented in Fig. 1. DNA isolation and mages of transformed E.coli DHS –α cells are presented in Plates 1 and 2, respectively. Gel image under UV – Transilluminator, showing the cloning confirmation by restriction enzyme digestion and PCR (Plate 3).
Figure 2 shows the BLAST Endoglucanase E1 result and Table 8 shows the sequencing validation of Endoglucauase E1. The results showed that at an amplification temperature of 55.90C, the endoglucanase E1 enzyme’s PCR product had a size of 659 bp. Using BLAST, we determined that the E1 sequencing findings were similar to other E1 gene-specific nucleotide sequences that are published in GenBank.
The result of the saccharification analysis in transfected in vitro shoot cultures regenerated from callus of Switchgrass (Panicum virgatum L.) is presented in Tables 11 & 12.
Discussion
The results of the study suggest that one cytokinin, specifically BAP, is the most effective for promoting shoot induction. In terms of reaction time, BAP outperformed Kn. Meristems, shoot tips, hypocotyls, epicotyls, seeds, leaf and tuber discs, root cuttings, and individual node cuttings are the usual explants used for micropropagation. However, in most cases, you can only directly initiate shoots from fully established tree explants,13,14 researchers looked into how BAP affected Aquilaria hirta shoot multiplication, elongation, and root induction in various basal medium. According to the findings, the basal medium worked best.15 Previous studies have demonstrated that shoot elongation typically decreases as the number of shoots in culture rises.16 The quantity of shoots likewise reduced as the cytokinin concentration increased. There was a noticeable decrease in shot quantity as the BAP content rose. Low amounts of cytokinin promote shoot regeneration, but high concentrations promote callus proliferation and hinder shoot differentiation.17 Among the two cytokinins we looked at, BAP alone produced more frequent shoots than Kn alone. This pattern of activity has also been observed in other plants, such as Murrayakoenigii L.,18 Aegle marmelos L.,19 and Feronia limonia L.20
According to the results of this study, only one cytokinin, BAP, was needed to trigger shoot bud induction and shoot proliferation. What’s more, as compared to when used in conjunction with auxins, BAP alone yielded better results in terms of shoot production density. This conclusion is in line with the claims made by several publications that BAP is enough to promote shoot proliferation in Tuberaria21 major, Metabriggsia sp., and Passiflora sp.22 The Kn-supplemented medium yielded more shoot buds than the BAP23 medium in the Houttuynia cordata experiment. Shot induction24 demonstrated, however, that BAP was superior to Kn.
It appears that employing a single cytokinin was the most effective strategy, according to the findings of the shoot induction. But when looking at BAP’s effects in isolation, it was clearly superior. Although increasing the concentration of cytokinin has minimal impact on the quantity of shoots generated, it is necessary for the induction of shoots. According to the data, the SG2(MS+0.3mg/l) treatment outperformed the other treatments significantly (P≤0.05). Buds broke later and shoots were narrower and shorter when cytokinin concentration was higher. Clumps of switchgrass (Panicum virgatum L.) were cultivated in a controlled setting to generate calluses. Research has shown that certain woody plant species, such as Ceratozamiahildae, Phoenix dactylifera, and Sesamum indicum, can generate calluses when exposed to combinations of 2, 4D and kinetin.25, 26 It is not uncommon for rooting and shoot multiplication to occur simultaneously in certain culture media. However, in order to encourage rooted and set up strong root growth, it is often necessary to transplant explants to new media that has different nutrients and different growth regulators27 discovered that reducing the medium mineral content to half of its usual strength greatly boosted rooting. Switchgrass (Panicum virgatum L.) shoots were shown to root most well in MS media. The rooting percentage that NAA alone produced was higher than that which it produced when combined with other hormones. It was also discovered that shoots of switchgrass (Panicum virgatum L.) rooted effectively in half strength MS media (1/2 MS). Results showed that half strength MS media supplemented with 0.1 mg/l IBA or NAA, 3 mg/1 activated charcoal, and 3% sucrose28 were the best conditions for root initiation and induction of Ficus anastasia. Similarly, among Ulmus species (elms), NAA resulted in the highest root development rate (percent).29 Although the fact that Panicum virgatum L. can regenerate from callus tissue utilizing invitro clumps as explants is promising, additional investigation into methods to expedite organogenesis in Panicum virgatum L. callus is required. For the purpose of cloning and expressing the EI gene into switchgrass, the Acidothermus cellulolyticus strain 11B and DNA were standardised using a variety of growth conditions and specific media. We got both of them from ATCC. The Acidothermus cellulolyticus strain 11B, used for cloning and EI gene expression, entered log phase after 36 hours of incubation at 55ᵚC in a shaking incubator. The culture was maintained in LPBSM, which stands for low phosphate basal salt media. This finding is in line with30 the optimal temperature of 55ẦC for the growth of Acidothermus cellulolyticus strain 11B. The physical investigation confirmed that Acidothermus cellulolyticus is a rod-shaped, nonmotile, Gram-negative bacterium. The negative results of the biochemical characterization tests performed using IMViC confirmed that the bacteria were Acidothermus cellulolyticus. The DNA isolated from the Acidothermus cellulolyticus culture was confirmed by agarose gel electrophoresis using a UV-transilluminator and a standard 1KB ladder. The E1 gene’s specific primers were designed by analyzing primer BLAST results from the NCBI. Primers are useful for this inquiry if their GC% is above 50, and self-replication is eliminated when their melting temperatures are close. All of these things were thought about when selecting high-quality primers. The E1 gene-specific primers were tested on Acidothermus cellulolyticus DNA using a gradient PCR analysis to determine the ideal annealing temperature. Acidothermus cellulolyticus’s E1 gene was found to be 98% identical to the E1 gene of the tested organism, according to BLAST results. Agarose gel electrophoresis confirmed the presence of an E1 gene insert (659 bp) and produced findings that were consistent with the size of the PCR product in our study, thereby validating the insert. A quantitative expression investigation in E. coli DH5-α validated the overexpression of the E1 gene. The E1 gene-specific primers and the RecA internal reference were used in a quantitative real-time polymerase chain reaction (QRT-PCR). A fold variation of 1.803% was demonstrated by the results. The E1 gene underwent amplification at 12 and 14 cycles, whereas the RecA gene, which serves as an internal control, underwent amplification at 25 and 28 cycles. The quantitative E1 gene analysis in transfected callus samples was validated by quick real-time polymerase chain reaction (QRT-PCR) and relative E1 gene expression levels. Actin, the internal control gene, showed its amplification at cycles 23 and 26, whereas the E1 gene’s amplification occurred at cycles 16 and 22, respectively. This study adds to the growing body of evidence suggesting successful transfection of the E1gene insert into the switch grass callus and subsequent mRNA expression.
According to the total protein content calculation, the callus shoot cultures that were transfected in vitro had a protein concentration of 0.58 mg/gm, which was greater than the non-transfected callus shoot cultures that were 0.311 mg/gm. Previous research has shown that the endoglucanase enzyme is active at alkaline pH and increases cellobiose release. This could mean that recalcitrance to biofuel generation31 is reduced, according to this study’s results on increased protein concentration in transfected in vitro shoot cultures from switchgrass callus. Saccharification results showed that endoglucanase enzymatic activity led to greater sugar release in transfected invitro shoot cultures from switchgrass callus (0.75 mg/g) than in non-transfected invitro shoot cultures from callus (0.315 mg/g). This study agrees with32 others about Phytochrome Interacting Factor 3. Increased saccharification efficiency was suggested by the observation of more soluble sugar release in transgenic switchgrass plants with an overexpressed Like 1 gene following enzymatic hydrolysis. Saccharification was found to be twofold improved in E1 transgenic switchgrass in vitro cultures at an optimal pH of 5.0, which is in agreement with prior study,33 which discovered a saccharification increase of up to 15% in E1 transgenic tobacco and maize grown at the same pH.
Cloning and Heterologous Expression of Endoglucanase E1 Enzyme for Improved Biofuel Production using Agrobacterium Mediated Gene Transfer Method
The gene of interest, Endoglucanase E1, was expressed in Acidothermus cellulolyticus11B, which was standardized in low phosphate basal salt medium (LPBSM) and acquired from the American Type Culture Collection (ATCC). Acidothermus cellulolyticus culture DNA was extracted using phenol-chloroform DNA isolation technique and DNA quality was assessed using Agarose Gel Electrophoresis. The Endoglucanase E1 gene was amplified and synthesized in bacterial DNA after being generated using primer BLAST. The Endoglucanase E1 gene was validated using sequencing analysis. The Endoglucanase E1 gene was inserted into a pUC18 vector after competent E. coli DH5-α cells were produced and screened. Polymerase chain reaction and restriction enzyme digestion validated the endoglucanase E1 gene insert. The Endoglucanase E1 gene’s quantitative expression in E.coliDH5-α was validated using Q-RT-PCR. Agrobacterium tumefaciens was transformed after having the endoglucanase E1 gene cloned into the expression vector pCAMBIA 1301. Transfection of the switchgrass callus with the selected Agrobacterium tumefaciens was performed. Using Q-RT-PCR, we were able to confirm that the Endoglucanase E1 gene was expressed quantitatively in the callus of Switchgrass.
Biochemical Screening of Transformed Invitro Shoot Cultures from Callus of Switchgrass (Panicum virgatum L.)
Protocols for biochemical screening were examined in order to determine the amount of sugar and total soluble protein. The influence of different concentrations of cytokinins (BAP and Kn) and auxins (NAA, IAA, and IBA) on shoot regeneration from callus cultures of switchgrass (Panicum virgatum L.) was studied in Kanamycin selection media.
To homogenize one gram of callus-regenerated shoot material, lysis buffer was added to a pre-chilled pestle and mortar. The following ingredients were used: 7 M urea, 2 M thiourea, 4% CHAPS, 100 mM DTT, 40 mM Tris-HCl (pH 8.5), and protease inhibitors. The protein extracts were spun at 12,000 revolutions per minute for 20 minutes at 4 degrees Celsius. The resulting supernatants were transferred to a new tube and portioned out for later use, keeping them at -80 degrees Celsius. The total soluble proteins were estimated using the Bradford test, which was performed on the supernatant.
Saccharification Analysis in Transfected Invitro Shoot Cultures Regenerated from Callus of Switchgrass (Panicum virgatum L.)
Invitro shoot cultures were cultivated in a controlled environment under 8 hours of light at 25°C from calluses of transfected and non-transfected switchgrass for saccharification. In the pots, the two cultures of shoots were allowed to dry. The internodes were used to harvest 4-millimeter-long portions of stem. The endoglucanase enzyme, which was generated from transgenic switchgrass cultures in vitro, was used for enzymatic hydrolysis. In a 25 mM sodium acetate buffer with a pH of 4.5, the hydrolysis process was carried out at predetermined intervals. Hydrolysis in 4% sulfuric acid at 120°C for one hour followed an initial dissolution of 4 mg of cultivated stem fragments in 72% sulfuric acid at 30°C for chemical hydrolysis. Following the neutralization of the hydrolysate with barium hydroxide [Ba(OH)₂], the sugar content was determined using Benedict’s technique. Using Benedict’s Quantitative Reagent, we measured the total sugar levels in cultures that were either left untreated or treated with endoglucanase.
Total Crude Protein Estimation in the Invitro Shoot Cultures from Transfected Callus
To homogenize one gram of callus-regenerated shoot material, lysis buffer was added to a pre-chilled pestle and mortar. The following ingredients were used: 7 M urea, 2 M thiourea, 4% CHAPS, 100 mM DTT, 40 mM Tris-HCl (pH 8.5), and protease inhibitors. The protein extracts were spun at 12,000 rpm for 20 minutes at 4°C. The resulting supernatants were spoon-fed into new tubes, portioned out, and kept at -80°C until needed. Tables 9 and 10 show the results of the Bradford test, which were used to estimate the total soluble protein concentration, from the supernatants. The Bradford test was used to evaluate total protein levels after crude protein was extracted from in vitro regenerated shoot cultures that were produced from callus.
Saccharification Analysis in Transfected Invitro Shoot Cultures Regenerated from Callus of Switchgrass (Panicum virgatum L.)
In vitro shoot cultures were established in a controlled environment with 8 hours of light at 25°C from calluses of transfected and non-transfected switchgrass. In their separate containers, the two shoot cultures were left to dry naturally. Sapcharification analysis required the collection of internode-region stem segments measuring 4 mm in length. All together, 4 milligrams of these stem pieces were dissolved in 72% sulfuric acid at 30 degrees Celsius, then hydrolyzed in 4% sulfuric acid at 120 degrees Celsius for an hour. After adding barium hydroxide [Ba(OH)2] to the resultant solution, it was neutralized. Then, the sugar content was found using Benedict’s method.
Table 1: Various Modified MS Media Used for Inducing Multiple Shoot Formation in Switchgrass (Panicum virgatum L.)
| Treatment Code. | BAP (mg/l) | NAA (mg/l) | IBA (mg/l) | IAA (mg/l) | Kn (mg/l) |
| SG 1 | 0 | 0 | 0 | 0 | 0 |
| SG 2 | 0.3 | 0 | 0 | 0 | 0 |
| SG 3 | 0.5 | 0 | 0 | 0 | 0 |
| SG 4 | 1 | 0 | 0 | 0 | 0 |
| SG 5 | 1.5 | 0 | 0 | 0 | 0 |
| SG 6 | 2 | 0.8 | 0 | 0 | 0 |
| SG 7 | 0.3 | 0 | 0.1 | 0 | 0 |
| SG 8 | 0.3 | 0 | 0 | 0.1 | 0 |
| SG 9 | 1 | 0.5 | 0 | 0 | 0 |
| SG 10 | 1 | 0 | 0.5 | 0 | 0 |
| SG 11 | 0 | 0 | 0 | 0 | 1 |
Note: Each treatment represents a different combination of plant growth regulators used in modified MS media to assess their effect on shoot multiplication.
Table 2: Shoot Proliferation and Development from Nodal Explants of Switchgrass (Panicum virgatum L.) in MS Media at 2 Months of Culture
| Treatment | Days to Bud Break | Leaf Length (cm) | Leaf Width (cm) | Number of Shoots | Subculture period (days) |
| SG1 | NA | 0 | 0 | 0 | NA |
| SG2 | 12 | 17 | 0.30 | 11 | 60 |
| SG3 | 14 | 11 | 0.20 | 7 | 60 |
| SG4 | 17 | 9 | 0.1 | 5 | 60 |
| SG5 | 28 | 4 | <0.1 | 3 | 60 |
| SG6 | 35 | 5 | <0.1 | 3 | 60 |
| SG7 | 38 | 11 | <0.1 | 4 | 60 |
| SG8 | 38 | 9 | <0.1 | 4 | 60 |
| SG9 | 43 | <5 | <0.1 | <3 | 60 |
| SG10 | 43 | <5 | <0.1 | <3 | 60 |
| SG11 | 20 | 5 | <0.1 | 4 | 60 |
Table 3: Different Media Combinations Tested for Callus Induction from invitro Clumps of Switchgrass (Panicum virgatum L.)
| Treatment Code | Medium | Kn(mg/l) | 2,4-D(mg/l) |
| SOC-1 | MS | 0.1 | 2 |
| SOC-2 | MS | 0.5 | 2 |
| SOC-3 | MS | 0 | 2 |
| SOC-4 | MS | 0.1 | 1 |
| SOC-5 | MS | 01 | 2 |
| SOC-6 | MS | 1 | 1 |
| SOC-7 | MS | 0 | 4 |
| SOC-8 | MS | 0.1 | 4 |
| SOC-9 | MS | 0 | 0 |
| SOC-10 | B5 | 0.1 | 2 |
| SOC-11 | B5 | 0.5 | 2 |
| SOC-12 | B5 | 0 | 2 |
| SOC-13 | B5 | 0.1 | 2 |
| SOC-14 | B5 | 1 | 2 |
| SOC-15 | B5 | 1 | 1 |
| SOC-16 | B5 | 0 | 4 |
| SOC-17 | B5 | 0.1 | 2 |
| SOC-18 | B5 | 0 | 0 |
| SOC-19 | MS+B5 | 0.1 | 2 |
| SOC-20 | MS+B5 | 0.5 | 2 |
| SOC-21 | MS+B5 | 0 | 2 |
| SOC-22 | MS+B5 | 0.1 | 0 |
| SOC-23 | MS+B5 | 1 | 2 |
| SOC-24 | MS+B5 | 1 | 1 |
| SOC-25 | MS+B5 | 0 | 4 |
| SOC-26 | MS+B5 | 0.1 | 4 |
| SOC-27 | MS+B5 | 0 | 0 |
Note: This table summarizes the various treatments combining different media (MS, B5, and their mixture) with varying concentrations of Kinetin (Kn) and 2,4-Dichlorophenoxyacetic acid (2,4-D) for optimizing callus induction protocols in switchgrass.
Table 4: Different Modified MS Media Evaluated for Root Development in Regenerated Shoots of Switchgrass (Panicum virgatum L.)
| Treatment code | Basal Medium | Charcoal (mg/l) | NAA (mg/l) | IAA (mg/l) |
| SG1 | 1/2MS | 0 | 0 | 0 |
| SG2 | 1/2MS | 0 | 1 | 0 |
| SG3 | 1/2MS | 0 | 0 | 1 |
| SG4 | 1/2MS | 0 | 0.5 | 0.5 |
| SG5 | 1/2MS | 0 | 0 | 0.5 |
| SG6 | 1/2MS | 0 | 0.5 | 0 |
Table 5: Different Modified MS Media Evaluated for Shoot Induction from Callus Cultures of Switchgrass (Panicum virgatum L.)
| Treatment Code | BAP (mg/l) | NAA (mg/l) | IBA (mg/l) | IAA (mg/l) | Kn (mg/l) |
| SG01 | 0 | 0 | 0 | 0 | 0 |
| SG02 | 0.3 | 0 | 0 | 0 | 0 |
| SG03 | 0.5 | 0 | 0 | 0 | 0 |
| SG04 | 1 | 0 | 0 | 0 | 0 |
| SG05 | 1.5 | 0 | 0 | 0 | 0 |
| SG06 | 2 | 0.8 | 0 | 0 | 0 |
| SG07 | 0.3 | 0 | 0.1 | 0 | 0 |
| SG08 | 0.3 | 0 | 0 | 0.1 | 0 |
| SG09 | 1 | 0.5 | 0 | 0 | 0 |
| SG10 | 1 | 0 | 0.5 | 0 | 0 |
| SG11 | 0 | 0 | 0 | 0 | 1 |
| SG12 | 0 | 0 | 0 | 0 | 1 |
Table 6: Days to Bud Break, Shoot Length, Leaf Length, Width and Number of at 2 Months of Culture in MS Medium
| Treatment | Days to Bud Break | Shoot Length | Leaf Length | Leaf Width | Number of Leaves |
| Sg2 | 12a | 10b | 17c | 0.308c | 11c |
| Sg3 | 14b | 5.433a | 11b | 0.205b | 7b |
| Sg4 | 17c | 5.216a | 9a | 0.1083a | 5a |
Means with different superscripts within a column indicate significant difference at P<0.05
Table 7: Root induction (Days) of regenerated shoots from Nodal Explant of switchgrass in modified M.S Medium.
| Treatment | Root Induction (Days) |
| SGR2 | 13a |
| SGR6 | 25b |
| SGR4 | 30c |
Means with different subscripts P < 0.05
![]() |
Table 8: Sequencing confirmation of Endoglucanase E1 Gene |
Table 9: Bovine Serum Albumin Standards for Protein Estimation
| BSA mg/ml | OD | BSA mg/ml | Mean value | ||||
| 5 | 2.935 | 2.835 | 2.739 | 5 | 2.836 | ||
| 2.5 | 1.95 | 1.957 | 1.954 | 2.5 | 1.953 | ||
| 1.25 | 1.755 | 1.763 | 1.713 | 1.25 | 1.743 | m value | 0.4912 |
| 0.625 | 0.953 | 0.973 | 0.971 | 0.625 | 0.965 | ||
| 0.312 | 0.851 | 0.829 | 0.751 | 0.312 | 0.81 | C value | 0.5894 |
| 0.156 | 0.707 | 0.742 | 0.611 | 0.156 | 0.686 | ||
| 0.078 | 0.368 | 0.358 | 0.322 | 0.078 | 0.349 | ||
| 0.039 | 0.278 | 0.201 | 0.318 | 0.039 | 0.265 | ||
Table 10: Enzyme assay and determination of total soluble proteins transfected in vitro shoot cultures from callus of switchgrass
| Sample Name | OD Value at 595 nm | Total Protein Content | Mean Value of Total Protein Content (mg/g) |
| A | 0.745 | 0.31678 | 0.31134636 |
| 0.751 | 0.32899 | ||
| 0.731 | 0.28827 | ||
| B | 0.873 | 0.57736 | 0.58482628 |
| 0.87 | 0.57125 | ||
| 0.887 | 0.60586 |
Saccharification Analysis in Transfected Invitro Shoot Cultures Regenerated from Callus of Switchgrass (Panicum virgatum L.)
The result of the saccharification analysis in transfected in vitro shoot cultures regenerated from callus of Switchgrass (Panicum virgatum L.) ispresented inTables 11 & 12.
Table 11: Glucose Standards for Benedicts Estimation
| Glucose mg/ml | OD | Glucose mg/ml | Mean value | ||||
| 5 | 2.618 | 2.623 | 2.648 | 5 | 2.629 | ||
| 2.5 | 1.292 | 1.225 | 1.284 | 2.5 | 1.267 | ||
| 1.25 | 1.036 | 1.079 | 1.034 | 1.25 | 1.049 | m value | 0.424 |
| 0.625 | 0.871 | 0.875 | 0.843 | 0.625 | 0.864 | ||
| 0.312 | 0.731 | 0.784 | 0.777 | 0.312 | 0.764 | C value | 0.4423 |
| 0.156 | 0.651 | 0.624 | 0.696 | 0.156 | 0.657 | ||
| 0.078 | 0.389 | 0.396 | 0.381 | 0.078 | 0.388 | ||
| 0.039 | 0.182 | 0.124 | 0.124 | 0.039 | 0.145 | ||
Table 12: Saccharification of Invitro Shoot Culture
| Sample Name | OD Value at 595 nm | Total Sugar Content | Mean Value of Total Sugar Content (mg/g) |
| A | 0.565 | 0.28939 | 0.31533019 |
| 0.565 | 0.28939 | ||
| 0.598 | 0.36722 | ||
| B | 0.776 | 0.78703 | 0.75086478 |
| 0.787 | 0.81297 | ||
| 0.719 | 0.65259 |
L AC AC
![]() |
Plate 1: DNA Isolation of the Acidothermus cellulolyticus |
![]() |
Plate 2: Images of Results of Transformed E.coli DH5-α Cells |
![]() |
Figure 1: Primer Design Using Primer BLAST Software |
![]() |
Figure 2: Description of BLAST Endo glucanase E1 |
![]() |
Plate 3: Gel Image under UV-Transilluminator Showing the Cloning Confirmation by Restriction Enzyme Digestion and PCR, |
Invitroshoot Regeneration from Callus of Switchgrass in Kanamycin Selection Media
Shoot regeneration from callus cultures of Switchgrass (Panicum virgatum L.) was investigated in this study utilizing a variety of cytokinin combinations (BAP and Kn) and auxins (NAA, IAA, and IBA) and individual cytokinins at varying doses inside Kanamycin selection medium.
Total Crude Protein Estimation in the Invitro Shoot Cultures from Transfected Callus
Table 8 displays the bovine serum albumin standards used for protein measurement. Transfected in vitro shoot cultures from switchgrass callus and enzyme assay for total soluble proteins are shown in Table 9.
Conclusion
Findings from this work have significant bearing on the development of methods for in vitro cultures of switchgrass and on the molecular screening of the Endoglucanase E1 gene from Acidothermus cellulolyticus in switchgrass shoot cultures for biofuel generation. It is possible to improve the efficiency of switchgrass biofuel production by using genetic engineering for biochemical screening and modifying in vitro culture conditions. Molecular screening of the Endoglucanase E1 gene from Acidothermus cellulolyticus in switchgrass cultures and the development of more efficient and sustainable in vitro protocols for switchgrass are both laid out by this research, which will help pave the way for a more sustainable energy future.
Biochemical screening confirmed the significant upregulation of the Endoglucanase E1 gene in in vitro switchgrass shoots, highlighting the possibility of genetic engineering to enhance switchgrass’s biofuel resource potential. Additional biofuel-related features can be introduced or improved upon by future investigation into genetic transformation experiments. To further improve biofuel production research, it is recommended to conduct additional chemical screening on transformed switchgrass plantlets that have been acclimated in greenhouses and to use bioreactors for sugar hydrolysis.
Acknowledgement
The authors wish to thank Tertiary Education Trust Fund (TETFund) for the National Research Fund (NRF) sponsored project and Contec Global Agro Ltd, Abuja for their support especially towards the success of invitro aspect of the research. We are also grateful to Phyto Technology Laboratories (Lenexa, KS), Sigma-Aldrich (St. Louis, Mo) and Trichy Research Institute of Biotechnology Pvt. Ltd, India for their contributions toward the genetic modification (GMF) phase of the research.
Funding Source
The research project was funded by Tertiary Education Trust Fund (TETFund) through the National Research Fund (NRF) 2020: TETFund/DR&D/CE/STI/52/VOL1.
Conflict of Interest
The authors do not have any conflict of interest
Data Availability Statement
This statement does not apply to this article
Ethics Statement
This research did not involve human participants, animal subjects, or any material that requires ethical approval.
Informed Consent Statement
This study did not involve human participants, and therefore, informed consent was not required.
Clinical Trial Registration
This research does not involve any clinical trials.
Permission to reproduce material from other sources
Not Applicable
Author Contributions
Rojin George: Tissue Culture Experiments, Methodology and Writing, Molecular and Biochemical Analyses.
Elizabeth Sahmicit Dashe: Field Trials, Section of Methodology, Molecular and Biochemical Analyses.
Josiah Chukwudi Onovo: Conceptualization, Section of Methodology and Writing, and Supervision.
References
- Bouton, J. H., Fasoula, V.A., and Missaoui, A. M. submitted in 2005. How low-density selection affects switchgrass biomass. The piece is in “Euphytica,” 142, 112.Read 10.1007/s10681-005-0149-y online.
- Zegada is a This information derives from a 2012 book by Lizarazu, Wullschleger, Nair, and Monti. Crop physiology. Pages 55–86 in Switchgrass, edited by Monti A., London: Springer. Access the complete version at the following link: https://doi.org/10.1007/978-1-4471-2903-5_3
CrossRef - Gelfand, I., Sahajpal, R., Zhang, X., Izaurralde, R.C., Gross, K.L., Robertson, G.P. (2013). Sustainable Midwest bioenergy production from marginal locations. Nature 493:514–517. https://doi.org/10.1038/nature11811
CrossRef - By Boe and Casler (2005). Switchgrass hierarchical morphology. Current Science 45:2465. Accessible at 10.2135/cropsci2004.0703.
CrossRef - H. Bouton (2007). Switchgrass molecular breeding for biofuels. Genetics & Development 17:553. https://doi.org/10.1016/j.gde.2007.08.012
CrossRef - The 2008 writers were Perrin, Vogel, Schmer, and Mitchell. Farm-scale switchgrass cultivation? Journal of Bioenergy, 1:91–97. The article is available at https://doi.org/10.1007/s12155-008-9005-y.
CrossRef - In 2008, the writers were Schmer, Vogel, Mitchell, and Perrin. The net energy of cellulosic ethanol derived from switchgrass. Proceedings of the National Academy of Sciences, USA, volume 105, pages 464-469. This publication contains the following DOI: 10.1073/pnas.0704767105
CrossRef - Shani, Z. O. Shoseyov, M. Abramson (2010). Rebuilding the plant cell wall improves processability and lignocellulosic yield. Plant science 178.61–72 (https://doi.org/10.1016)
CrossRef - Somerville, C., Youngs, H., Davis, S.C., Long, S.P. (2010). Feedstocks for Lignocellulosic Biofuels. Science 329: 790-79. https://doi.org/10.1126/science.1189268
CrossRef - (2009) Aden, A., &Fourst, T. Technoeconomic assessment of dilute sulfuric acid and enzymatic hydrolysis for corn stover-to-ethanol conversion. Cellulose 16:535-545. https://doi.org/10.1007/s10570-009-9327-8
CrossRef - Himmel, M.E., Ding, S.Y., Johnson, D.K., Adney, W.S., Nimlos, M.R., Brady, J.W. Biofuel biomass recalcitrance plant and enzyme engineering. Science 315, 804–807. https://doi.org/10.1126/science.1137016
CrossRef - A. Skoog and T. Murashige (1962). Tobacco tissue culture-based growth and bioassay media. Physiologia Plantarum 15, 473-497.
CrossRef - Trigiano, R. N., Geneve, R. L., Merkle, S. A., and Preece, J. E. (1992). Cell culture of woody leguminous tissues. Hort Rev, 14: 265-332.
CrossRef - H. Hassan, N. A. M. Ali, F. Zainudin, and H. Ismail (2011). BAP’s effect on Aquilaria hirta shoot proliferation in various basal media and detection of essential oils in in vitro shoots. African Journal of Biotechnology 10, 51, 10500–10503.
CrossRef - Borhakur, M., Dutta, K., Nath, S. C., and Singh, R. S. (2000). Micropropagation of Eclipta alba and Eupatorium adenophorum via a single-step nodal cutting method. Plant Cell Tissue Organ Culture, 62: 239-242.
CrossRef - Joshi, M. & Dhar, U. (2003). In vitro propagation of Saussureaobvallata (DC.) Egger, an endangered ethnoreligious medicinal herb of the Himalayas. Plant Cell Reports.
CrossRef - Kumar, U. (1999). Techniques in plant tissue culture. Published by Agro Botanika. New Delhi.
- Das, R., Hasan, M. F., Rahman, M. S., Rashid, M. H., and Rahman, M. (2008). In vitro wood apple (Aegle marmelos L.) multiple branch proliferation multiplication. Volume 3 of International Journal of Sustainable Crop Production
- Hiregoudar, L. V., Murthy, H. N., Hema, B. P., Hahn, E. J., and Paek, K. Y. (2003).
Induction of many shoots and regeneration of Feronia limonia (L.) Sgle, Scientia Horticulturae. - Lemežienė, N. E. Norkevičienė, T. Liatukas, G. Dabkevičienė, J. Cecevičienė, and B. Butkutė (2015). Northern European energy crop North Dakota switchgrass is adaptable and promising. Acta Agriculturae Scandinavica 65:118–124:Soil and Plant Science.
CrossRef - Uzma, M. M. Sharma, N. Ismail, and A. Batra (2012). Murraykoenigii (L.) Spreng immature seed regeneration in vitro. Indian Biotechnology Journal Pages 16-20.
- Goncalves, S., Fernandes, L., and Romano, A. (2010). Rapid in vitro multiplication of the rare species Tuberaria major. Plant Cell Tissues Organ Culture, 101, 359-363.
CrossRef - Garcia, R., Pacheco, G., Falcao, E., Borges, G., & Mansur, E. (2011). Impact of explant type, plant growth regulators, salt composition of the basal media, and light conditions On callogenesis and regeneration in Passiflora suberona L. (Passifloraceae). Plant Cell Tissue Organ Culture, 106: 47-54.
CrossRef - Chakrabarti, S., Sinha, S., & Sinha, R. K. (2006). Frequent induction of numerous shoots and clonal proliferation from rhizomatous nodal segments of Houttuynia cordata Thunb., an ethnomedicinal herb of India. In Vitro Cellular and Developmental Biology,
CrossRef - Magyar-Tabori, K., Dobranskzi, J., Teixeira da Silva, J. A., Bulley, S. M., and Hudak, I. (2010). The function of cytokinins in shoot organogenesis in Malus domestica. Plant Cell Tissue. Organ Culture, 101: 251-267. https://doi.org/10.1007/s11240-010-9696-6
CrossRef - Omar, M. S. & Novak, F. J. (1990). In vitro plant regeneration and ethyl methanesulfonate (EMS) absorption in somatic embryos of date palm (Phoenix dactylifera). Plant Cell Tissue and Organ Culture,
CrossRef - Rao, R. & Vaidyanath, K. (1997). Cellular induction and morphogenesis in sesame (Sesamum indicum). Advances in Plant Science, 10(2):21-26.
- Fotopolous, S. & Sotiropoulos, T. E. (2005). In vitro rooting of PR 204/84 rootstock (Prunus persica × Prunus amygdalus) as affected by mineral content of the culture media and duration of darkness exposure. Agronomy Research, 3(1):3-8.
- Ameena, A., Malki, H. S., and Suliman Elmeer, K. M. (2009). Impact of medium strength and the combination of charcoal with IBA and NAA on root initiation in Ficus Anastasia. Academic Journal of Plant Science, 2(3):169-172.
- Durkovic, J. & Misalova, A. (2008). An overview of micropropagation techniques for temperate noble hardwoods. Functional Plant Science and Biotechnology, Global Science Books, pages 1-19.
- Ding, S.Y., & Himmel, M.E. (2006). A novel model of the maize primary cell wall microfibril obtained through direct viewing. Journal of Agricultural and Food Chemistry, 54(3):597-606.
CrossRef - Willis, J.M., Grant, J.N., Mazarei, M., Kline, L.M., Rempe, C., Collins, A.G., Turner, G.B., Decker, S.R., Sykes, R.W., Davis, M.F., Labbe, N.J., Jurat-Fuentes, J.L., & Stewart, C.N. (2017). The TcEG1 beetle (Tribolium castaneum) cellulase generated in transgenic switchgrass exhibits activity at alkaline pH and undergoes auto-hydrolysis of biomass, enhancing cellobiose release. Biotechnology for Biofuels, 10.
CrossRef - Yan, J., Liu, Y., Wang, K., Li, D., Hu, Q., & Zhang, W. (2018). The overexpression of OsPIL1 improved biomass yield and saccharification efficiency in switchgrass. PlantScience: An International Journal of Experimental Plant Biology, 276:143-151.
CrossRef

This work is licensed under a Creative Commons Attribution 4.0 International License.